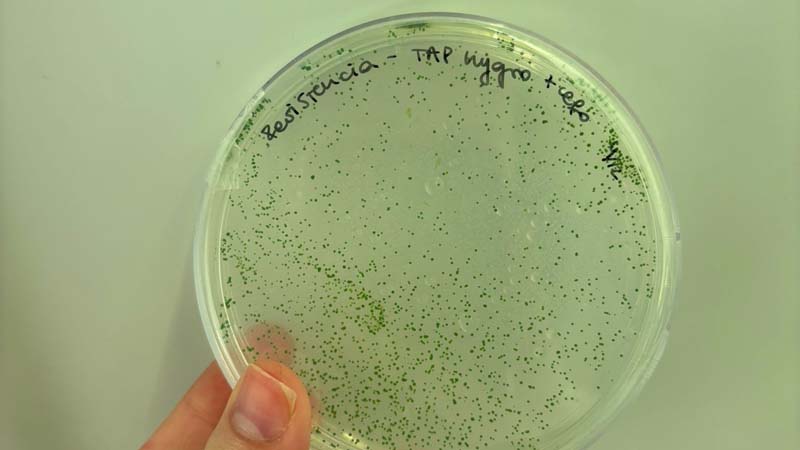
Ingenier&iacute;a en Biotecnolog&iacute;a

El emprendimiento PhycoTech está integrado por tres estudiantes de Ingeniería en Biotecnología, Fiorella Toniotti, Marcia Martínez y Matilde Klett, y un graduado de la carrera, Facundo Rocha.
El proyecto surge como tesis de grado y hoy avanza como una startup biotecnológica con proyección internacional, combinando investigación académica y espíritu emprendedor.
Microalgas como plataforma biotecnológica
PhycoTech trabaja con microalgas modificadas genéticamente para la producción de proteínas recombinantes, con foco inicial en la industria cosmética. Las microalgas presentan múltiples ventajas frente a otros sistemas productivos: son fáciles de cultivar, requieren menos nutrientes, tienen costos más bajos y son bioseguras para su uso en contacto con la piel humana.
Además, poseen de forma natural propiedades antioxidantes, antiinflamatorias, fotoprotectoras y proliferativas, lo que las convierte en una plataforma atractiva para el desarrollo de ingredientes cosméticos innovadores.
Un valor agregado para la industria cosmética
A esas propiedades intrínsecas, el equipo suma un diferencial clave: la expresión de proteínas específicas, que permite desarrollar tratamientos más dirigidos y eficientes.
“Es como agregarle una capa extra de funcionalidad a algo que ya de por sí tiene muchos beneficios”, explica Fiorella Toniotti, y destaca el potencial de la biotecnología para crear productos más personalizados.
Del laboratorio al emprendimiento
Aunque el proyecto nació en el ámbito académico, el paso hacia el emprendedurismo fue acompañado por la propia formación de la carrera. A lo largo de sus estudios, las integrantes cursaron materias vinculadas a bionegocios, gestión y economía, que las acercaron a la lógica empresarial y les permitieron imaginar un camino más allá del laboratorio.
En ese proceso, el Centro de Innovación y Emprendimientos (CIE) de la universidad tuvo un rol central, brindando orientación, mentorías y apoyo para transformar la idea científica en un emprendimiento con potencial comercial.
Premios que impulsan el proyecto
PhycoTech recibió varios reconocimientos y apoyos económicos que resultaron fundamentales para avanzar en el desarrollo del proyecto y validar su propuesta.
Entre los principales se destacan:
- VIN – Validación de la idea, con un apoyo económico de USD 5.000, que permitió dar los primeros pasos y validar la plataforma biotecnológica.
- Premio Nuevo Talento Emprendedor, otorgado por la Asociación Gallega de Empresarios del Uruguay, que incluye USD 5.000 y una experiencia formativa vinculada al Camino de Santiago.
- Start Fellowship, un programa internacional que permitirá a Matilde Klett participar durante cuatro meses en una aceleradora en Suiza, donde recibirá formación en validación de modelos de negocio, mentorías especializadas y una financiación adicional cercana a los USD 7.000, además de la posibilidad de contacto con inversores internacionales.
“Estos premios son una validación que te empuja a seguir y a creer que la idea tiene sentido”, señala Marcia Martínez.
Aprender a pensar como empresa
Además de los premios, las integrantes participaron en programas de mentoría como CITES y otras instancias formativas, donde comenzaron a trabajar aspectos clave como propiedad intelectual, modelo de negocios, estrategia comercial y escalabilidad.
“Venimos del mundo científico y aprender a pensar como empresa es todo un proceso”, reconoce Marcia, y agrega que estas instancias les permiten incorporar miradas complementarias sin perder el foco académico.

Próximos pasos: escalar y salir al mercado
A mediano plazo, el objetivo del equipo es avanzar hacia una escala piloto que permita producir el ingrediente en mayores volúmenes. Para eso, buscan alianzas con empresas que aporten infraestructura y experiencia en escalado industrial.
En paralelo, están generando primeros acercamientos con una empresa cosmética, han recibido asesoramientos respecto a formulaciones y validación del producto, y proyectan generar contactos en Europa y Estados Unidos para explorar nuevos mercados y posibles colaboraciones.
Un mercado en crecimiento
El primer mercado al que apunta PhycoTech es el de la cosmética, un sector en expansión y cada vez más interesado en ingredientes sustentables y procesos productivos más verdes.
“Es un mercado que está creciendo mucho y que busca alternativas más verdes”, afirma Fiorella, aunque reconoce que el tamaño del mercado local también plantea desafíos.
Un mensaje para otros estudiantes
Desde PhycoTech, el mensaje para quienes quieren emprender en biotecnología es claro: animarse.
“Hablar las ideas, acercarse a docentes, al CIE, pedir ayuda y validar”, recomienda Marcia Martínez. “Las herramientas están y el apoyo también”.
Para el equipo, la carrera no solo brinda una sólida formación científica, sino también la posibilidad de transformar ideas en proyectos reales, con impacto y proyección.
Conocé más sobre Ingeniería en Biotecnología